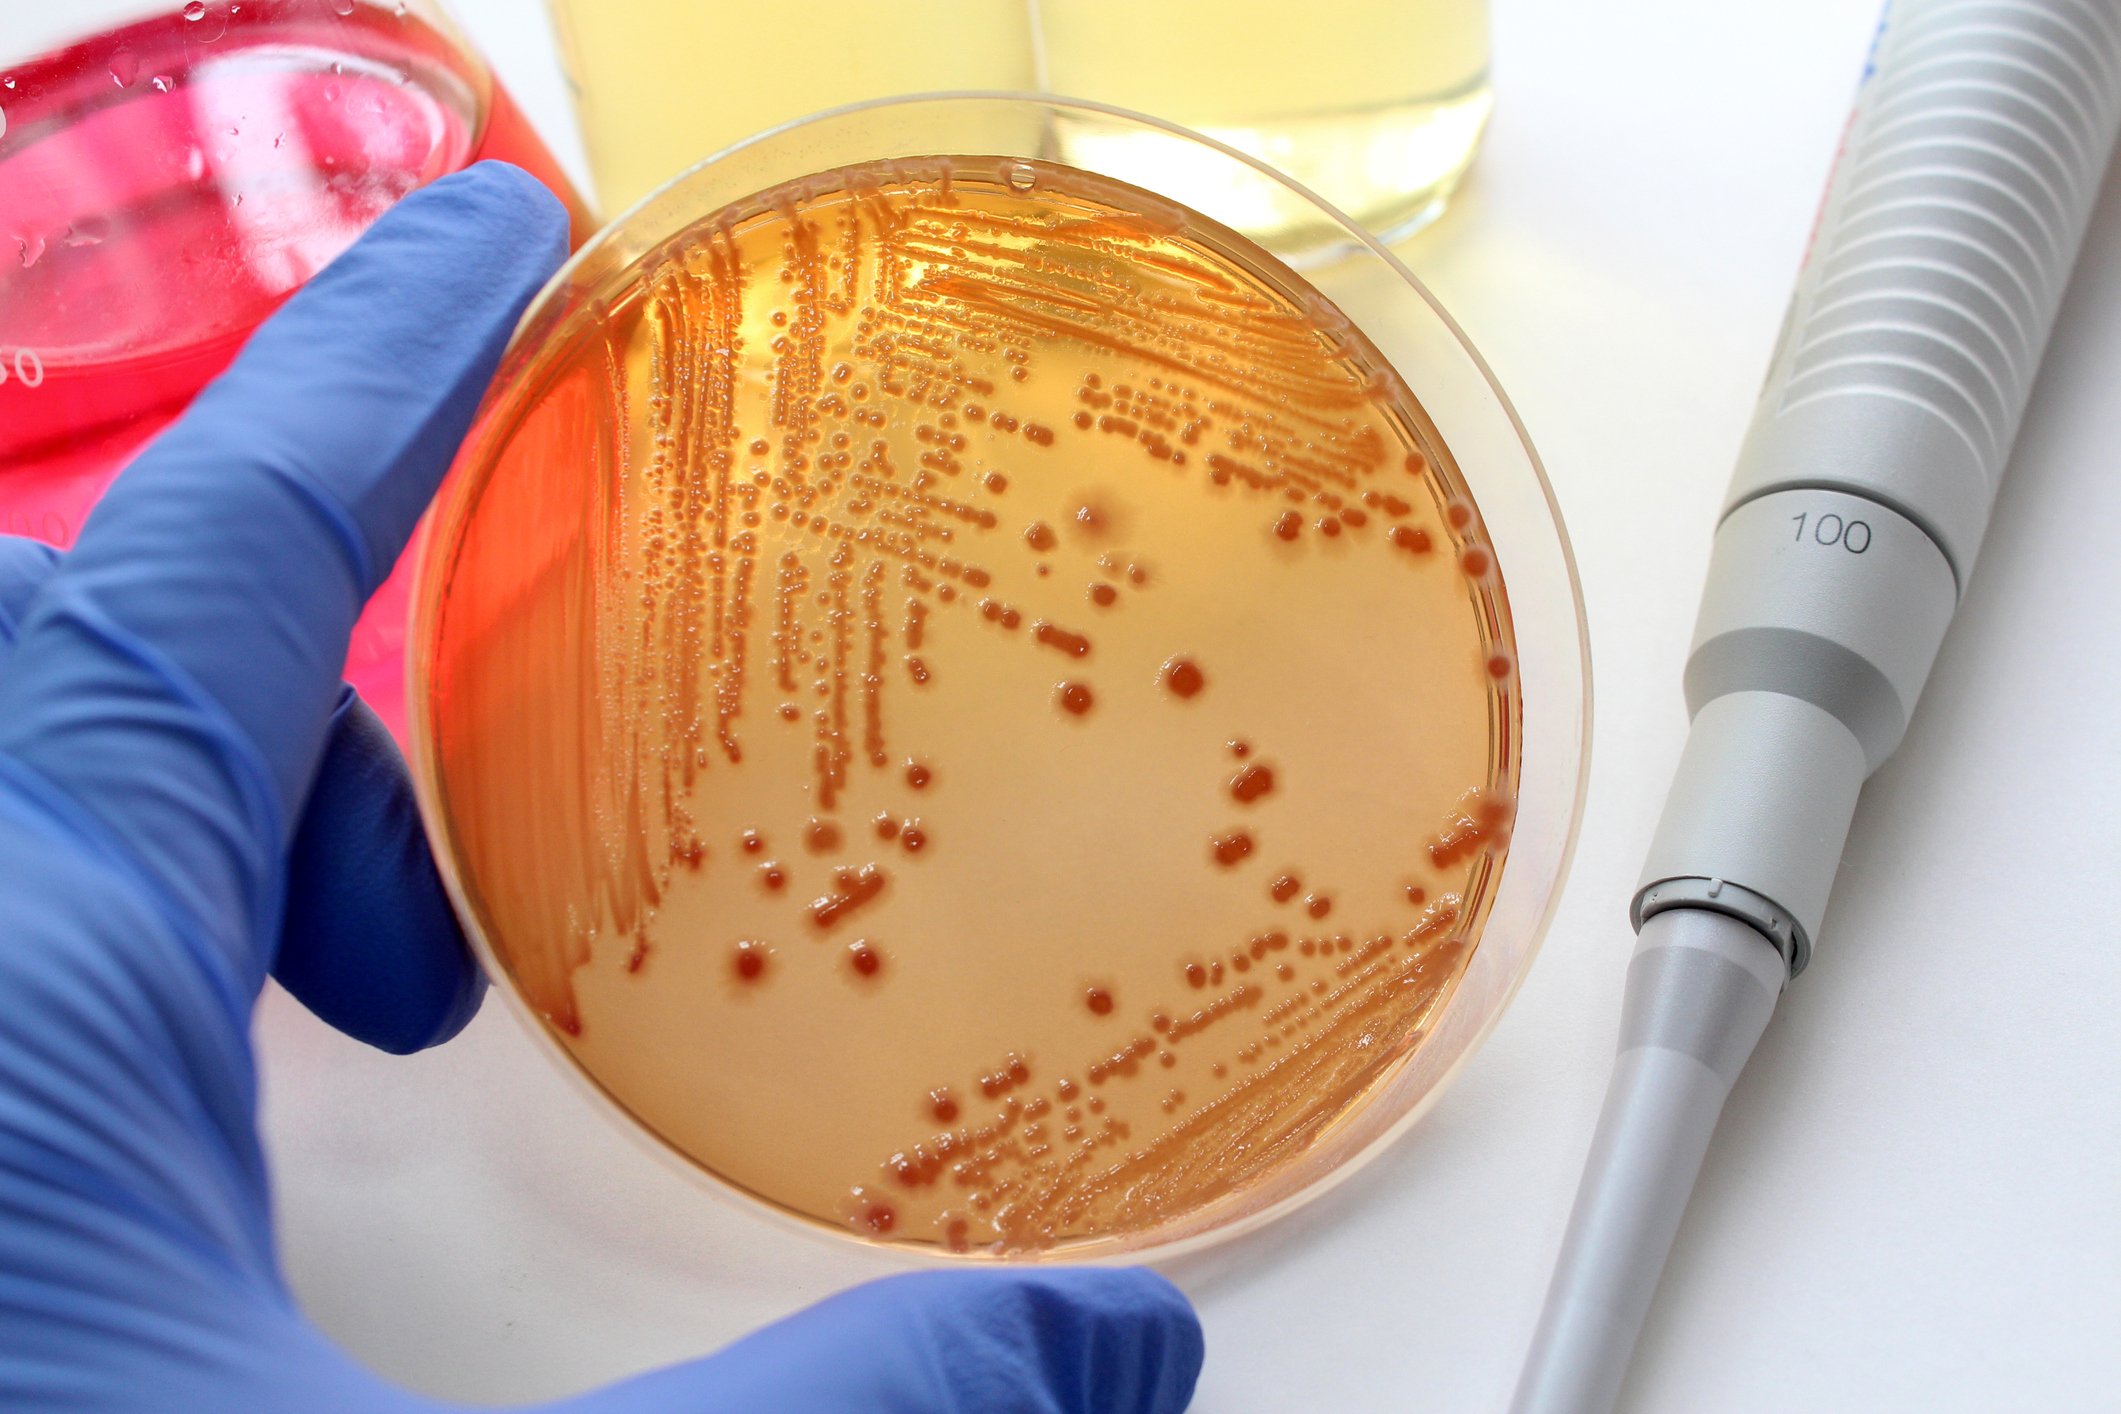

Information
Senior Lecturer
Department of Biological Sciences
Faculty of Natural Sciences and Life
University of Souk Ahras
Souk Ahras - 41000. Algeria
r.batah@univ-soukahras.dz
https://univ-soukahras.dz/en/profile/rbatah
Teaching
Module | Level | Speciality |
---|---|---|
Medical parasitology and mycology | Master - S3 | Microbiology |
English | Bachelor - S5 | Ecology and Environment |
Scientific English | Bachelor - S5 | Aquaculture and fish farming |
Scientific English | Bachelor - S5 | Food science |
Scientific English | Bachelor - S5 | Food science |
Molecular biology | Bachelor - S6 | Biochemistry |
Scientific English | Bachelor - S6 | Biochemistry |
Englisn | Bachelor - S6 | Biology and Plant Physiology |
English | Bachelor - S6 | Animal Biology and Physiology |
English | Bachelor - S6 | Biology and ecology of aquatic environments |
Microbial genetics | Bachelor - S6 | Microbiology |
Scientific English | Bachelor - S6 | Microbiology |